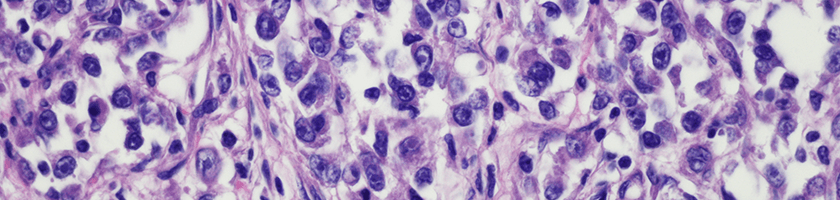
sarcoma

Types of Sarcoma
Sarcomas can affect muscle, fat, nerves, tendons, bones, and joints as well as the vessels of the circulatory and lymph systems.
Read about the types of sarcoma.
Explore this Section
Sarcoma is a family of cancers that form in the soft tissues and in bone.
These diseases are rare. Doctors diagnose only about 12,000 people with sarcoma each year in the United States.
No sarcoma is the same and a diagnosis affects each person differently. Developing an effective treatment plan requires input from a variety of specialists.
To learn more about sarcoma care or to make an appointment, you can:
At UPMC Hillman Cancer Center, your sarcoma team is comprised of specialists who review your specific situation and work together to determine the most appropriate treatment plan, tailored to you.
Sarcoma Specialty Care at UPMC Hillman Cancer Center brings together a multidisciplinary team of leading experts in:



Learn more about pain management services.
Learn more about nutrition services.
Learn more about palliative care.
Together we tailor complete, compassionate care to meet your needs at every stage of your sarcoma treatment.

Types of Sarcoma
Sarcomas can affect muscle, fat, nerves, tendons, bones, and joints as well as the vessels of the circulatory and lymph systems.
Read about the types of sarcoma.
Sarcoma Treatment Program
Sarcoma Specialty Care at UPMC Hillman Cancer Center brings together experts in oncology, radiology, pathology and orthopaedic surgery.
Learn more about our Sarcoma Treatment Program.
Treatments for Sarcoma
There are many treatment options for sarcoma, including medical oncology, radiation, and surgery.
Read more about treatment options.
Understanding the Different Types of Bone Cancer
Three of the most common types of primary bone cancer are osteosarcoma, Ewing’s sarcoma, and chondrosarcoma.
Learn more from UPMC HealthBeat.